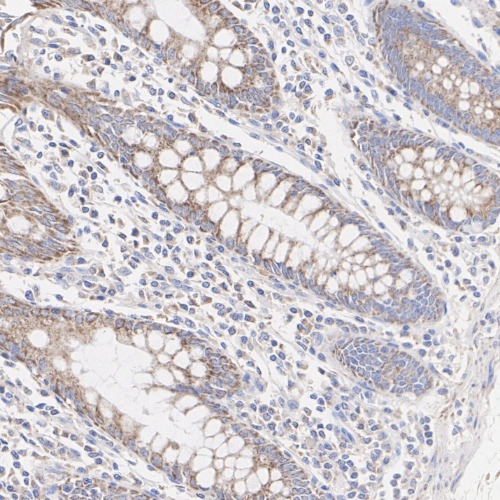

MCU Mouse Monoclonal Antibody(ARA997)
|
Application |
Dilution Ratio |
|
WB |
1:1000 - 1:5000 |
|
IHC |
1:20 - 1:50 |
|
ICC/IF |
1:20 - 1:50 |
|
Antibody Type |
Mouse Monoclonal Antibody |
|
Immunogen |
Recombinant protein within Human MCU aa 51-325 / 351. |
|
Species Reactivity |
Human, Mouse, Rat, Monkey |
|
Validated Applications |
WB, IHC-P, IF-Cell |
|
Molecular Weight |
Predicted band size: 40 kDa |
|
Positive Control |
HCT 116 cell lysate, PANC-1 cell lysate, A549 cell lysate, Hela cell lysate, COS-1 cell lysate, NIH/3T3 cell lysate, C2C12 cell lysate, C6 cell lysate, PC-12 cell lysate, Mouse colon tissue lysate, Mouse testis tissue lysate, Rat colon tissue lysate, Rat heart tissue lysate, human colon tissue, human colon cancer tissue, HCT 116, NIH/3T3, C6. |
|
Conjugation |
unconjugated |
|
Form |
Liquid |
|
Storage Buffer |
PBS (pH7.4), 0.1% BSA, 40% Glycerol. Preservative: 0.05% Sodium Azide. |
|
Isotype |
IgM |
|
Purification Method |
Protein A affinity purified. |

Western blot analysis of MCU on different lysates with MCU Mouse Monoclonal Antibody(ARA997).
Immunohistochemical analysis of paraffin-embedded human colon tissue with MCU Mouse Monoclonal Antibody(ARA997).

Immunocytochemistry analysis of C6 cells labeling MCU with MCU Mouse Monoclonal Antibody(ARA997).
 New Products
New Products






















